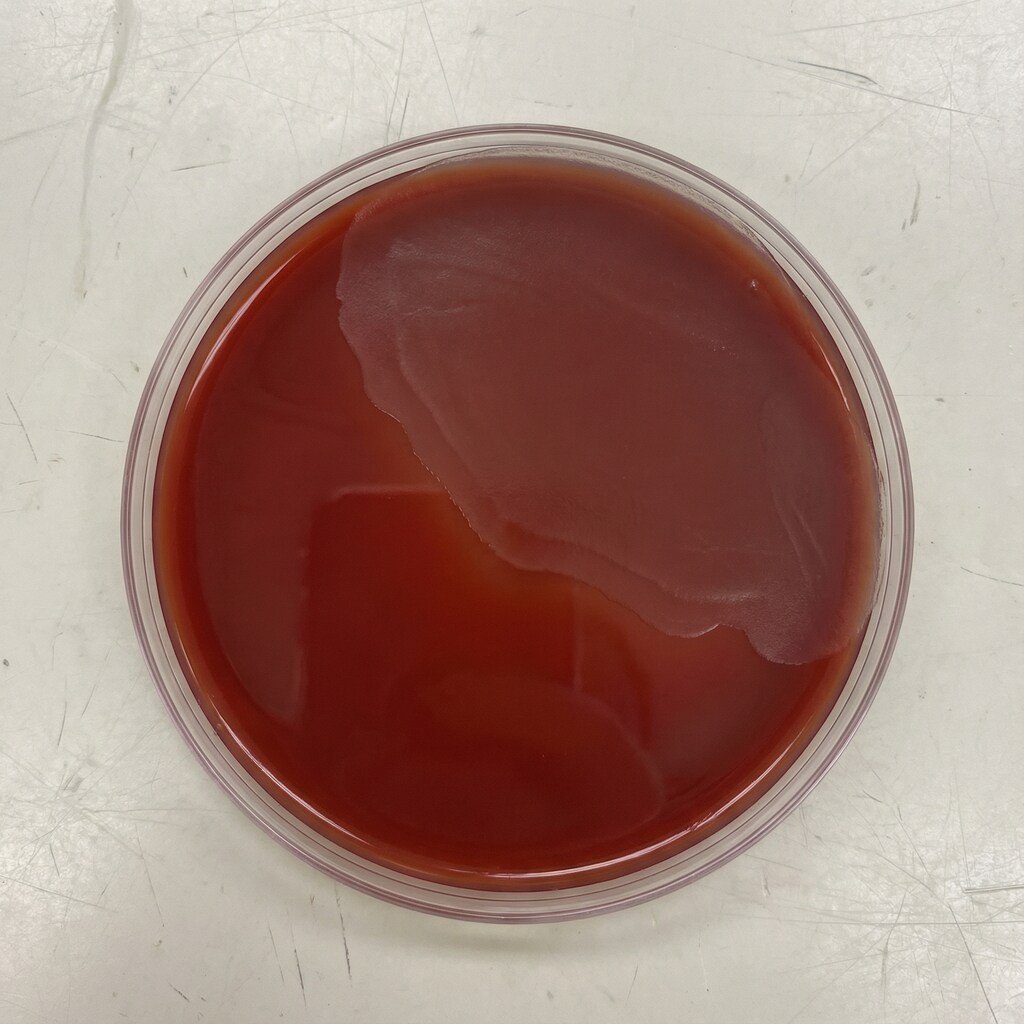
血液寒天培地上の破傷風菌（Clostridium tetani）観察写真

血液寒天培地上の破傷風菌(Clostridium tetani)観察写真
使用したAI
Gemini
GPTの真贋判定は、一瞬ではフェイクと断定できない、ですって。
β溶血が弱いのが気になるけどあり得るレベル。
画角が正円過ぎて怪しいけれど、スマホ持ってる手が映り込んでて本物っぽいらしい。
使ってもバレないかな?
β溶血が弱いのが気になるけどあり得るレベル。
画角が正円過ぎて怪しいけれど、スマホ持ってる手が映り込んでて本物っぽいらしい。
使ってもバレないかな?
呪文
呪文を見るにはログイン・会員登録が必須です。
イラストの呪文(プロンプト)
jacket partially removed, heart in eye, burnt clothes, holding fishing rod, kanji, doujin cover, pentagram, tape gag, adjusting headwear, red socks, friends, cloud print, coke-bottle glasses, oral invitation, competition school swimsuit, barbell piercing, gradient legwear, prisoner, blood on breasts, wind chime, carrying over shoulder, tape measure, flaming weapon
イラストの呪文(ネガティブプロンプト)
入力なし